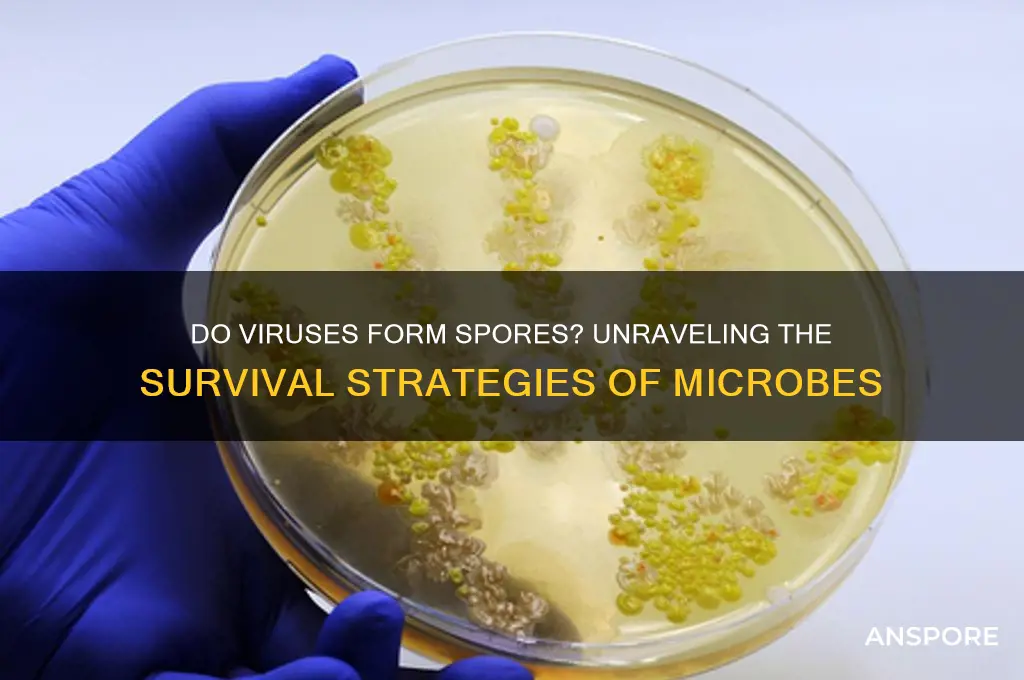
can viruses form spores

Viruses are obligate intracellular parasites that rely on host cells to replicate and survive, and they lack the cellular machinery necessary for forming spores. Sporulation is a process typically associated with certain bacteria, fungi, and plants, where a protective, dormant structure is created to withstand harsh environmental conditions. Unlike these organisms, viruses do not possess the biological mechanisms or structures required for spore formation. Instead, viruses often survive outside hosts by remaining in a stable, non-replicative state, protected by their protein capsids or envelopes, but this does not constitute sporulation. Therefore, viruses cannot form spores, as their survival strategies are fundamentally different from those of spore-forming organisms.
| Characteristics | Values |
|---|---|
| Can viruses form spores? | No |
| Reason | Viruses lack the cellular machinery and metabolic processes necessary for sporulation |
| Sporulation | A process unique to certain bacteria, fungi, and plants, involving the formation of a protective spore |
| Viral survival strategies | Viruses can survive outside hosts through: |
- Encapsidation (protective protein coat)
- Lipid envelope (in enveloped viruses)
- Attachment to surfaces or fomites
- Persistence in the environment (e.g., in water, soil, or on surfaces)
Explore related products
What You'll Learn
- Virus vs. Bacteria Spores: Viruses lack cellular structure, so they cannot form spores like bacteria
- Survival Strategies: Viruses survive via latency, desiccation resistance, or host persistence, not spore formation
- Environmental Persistence: Viruses remain dormant in harsh conditions without forming spores
- Capsid Protection: Viral capsids shield genetic material, enabling survival without spore-like structures
- Misconceptions Clarified: Spores are exclusive to prokaryotes; viruses use alternative mechanisms for longevity

Virus vs. Bacteria Spores: Viruses lack cellular structure, so they cannot form spores like bacteria
Viruses and bacteria are both microscopic entities, but their survival strategies differ fundamentally due to their structural disparities. Bacteria, being single-celled organisms with a cellular structure, can form spores—dormant, highly resistant cells that enable them to endure harsh conditions like extreme temperatures, radiation, and desiccation. These spores can remain viable for years, reactivating when conditions improve. For example, *Clostridium botulinum* forms spores that survive in soil and food, posing risks if ingested. In contrast, viruses lack cellular machinery entirely; they are merely genetic material encased in a protein coat. Without the cellular framework necessary for sporulation, viruses cannot form spores. Instead, they rely on host cells for replication and survival, making their persistence dependent on environmental factors like moisture and temperature.
To understand why viruses cannot form spores, consider their structural simplicity. Viruses are obligate intracellular parasites, meaning they cannot replicate or metabolize independently. They lack ribosomes, mitochondria, and other cellular components essential for life processes. Sporulation, a complex process involving DNA condensation, cell wall thickening, and energy expenditure, is beyond their capabilities. Bacteria, on the other hand, possess the metabolic and structural tools to initiate sporulation when resources are scarce. For instance, *Bacillus anthracis* forms spores in response to nutrient depletion, ensuring long-term survival. This distinction highlights the evolutionary divergence between viruses and bacteria, with sporulation being a bacterial-specific adaptation.
From a practical standpoint, the inability of viruses to form spores has significant implications for disinfection and sterilization. Bacterial spores, such as those of *Geobacillus stearothermophilus*, are notoriously resistant to heat and chemicals, requiring extreme measures like autoclaving at 121°C for 15–30 minutes to ensure their destruction. Viruses, however, are generally more susceptible to environmental stressors. Common disinfectants like 70% ethanol or 0.5% hydrogen peroxide can inactivate many viruses by disrupting their protein capsids or lipid envelopes. For example, SARS-CoV-2, the virus causing COVID-19, is effectively neutralized by these agents within minutes. Understanding this difference allows for targeted strategies to control viral and bacterial contamination in healthcare, food processing, and other industries.
While viruses cannot form spores, they have evolved alternative mechanisms to ensure survival outside hosts. Some, like norovirus, are highly resistant to desiccation and can persist on surfaces for weeks. Others, such as influenza virus, remain infectious in respiratory droplets for hours. These adaptations, though not sporulation, enable viruses to spread efficiently in diverse environments. In contrast, bacterial spores are a long-term survival strategy, allowing organisms to endure decades in adverse conditions. This comparison underscores the importance of tailoring control measures to the unique biology of each pathogen, whether it involves sporulation or not.
In summary, the inability of viruses to form spores stems from their lack of cellular structure, a feature that distinguishes them from bacteria. While bacteria use sporulation as a survival mechanism, viruses rely on host cells and environmental resilience. This fundamental difference dictates how we approach their control, from disinfection protocols to public health strategies. Recognizing these distinctions ensures effective management of both viral and bacterial threats, safeguarding health and safety across various contexts.
Wireless Printing on a Hot Spot: Tips and Tricks for Success
You may want to see also

Survival Strategies: Viruses survive via latency, desiccation resistance, or host persistence, not spore formation
Viruses, unlike bacteria, do not form spores as a survival mechanism. This fundamental difference highlights the unique strategies viruses employ to endure harsh conditions. While bacterial spores are dormant, highly resistant structures capable of withstanding extreme environments, viruses rely on alternative methods to persist outside their hosts. Understanding these mechanisms—latency, desiccation resistance, and host persistence—sheds light on viral survival and informs strategies to combat them.
Consider latency, a stealthy survival tactic where viruses integrate their genetic material into the host’s DNA, lying dormant until conditions favor reactivation. Herpes simplex virus (HSV) exemplifies this, remaining latent in nerve cells for years before resurfacing as cold sores. This strategy ensures long-term survival without the need for spore formation. For instance, individuals infected with HSV-1 may experience recurrent outbreaks triggered by stress, sunlight, or weakened immunity, demonstrating the virus’s ability to persist silently.
Desiccation resistance is another critical survival mechanism, particularly for viruses transmitted via fomites or aerosolized particles. Norovirus, a leading cause of viral gastroenteritis, can survive on surfaces for weeks, remaining infectious even in dry conditions. This resilience is attributed to its protein capsid structure, which protects the viral genome. Practical measures, such as using disinfectants containing at least 62% ethanol or sodium hypochlorite (bleach), are essential to inactivate these viruses on surfaces, reducing transmission risks.
Host persistence, the third strategy, involves continuous replication within a host population, ensuring viral survival without external resistance. HIV illustrates this, establishing lifelong infections by integrating into immune cells and evading eradication. Antiretroviral therapy (ART) suppresses viral replication but does not eliminate the virus, underscoring the challenge of combating persistent infections. Similarly, influenza viruses evolve rapidly through antigenic drift, maintaining their presence by circulating in human and animal populations.
In contrast to spore formation, these viral survival strategies emphasize adaptability and reliance on hosts or environmental resilience. While bacterial spores can survive for centuries, viruses depend on dynamic interactions with their surroundings. For example, vaccinia virus, used in smallpox vaccination, can persist in scab material, requiring careful handling of vaccine sites to prevent transmission. This highlights the importance of tailored interventions—such as antiviral medications, hygiene practices, and vaccination—to disrupt viral survival mechanisms effectively.
Ultimately, recognizing that viruses do not form spores but instead employ latency, desiccation resistance, and host persistence reframes our approach to viral control. By targeting these specific strategies, we can develop more effective prevention and treatment measures, from antiviral drugs that disrupt latency to surface disinfection protocols that counteract desiccation resistance. This nuanced understanding of viral survival is key to mitigating their impact on human health.
Can Mold Spores Bite? Unraveling the Truth Behind the Myth
You may want to see also

Environmental Persistence: Viruses remain dormant in harsh conditions without forming spores
Viruses, unlike bacteria, do not form spores as a survival mechanism. Yet, they exhibit remarkable environmental persistence, remaining dormant in harsh conditions through alternative strategies. This ability allows them to withstand extreme temperatures, desiccation, and exposure to UV radiation, ensuring their survival until favorable conditions return. For instance, the poliovirus can persist in water for weeks, while the influenza virus remains viable on surfaces for up to 48 hours. Understanding these mechanisms is crucial for developing effective disinfection protocols and controlling viral spread.
One key strategy viruses employ is their protective protein capsid, which shields the genetic material from environmental stressors. For example, norovirus, a common cause of gastroenteritis, can survive on stainless steel surfaces for up to 28 days due to its robust capsid structure. Additionally, some viruses, like the hepatitis A virus, can form clumps or aggregate with organic matter, enhancing their stability in the environment. These adaptations highlight the importance of thorough cleaning and disinfection, especially in high-risk areas like hospitals and food preparation surfaces.
Another factor contributing to viral persistence is their ability to associate with biofilms, complex communities of microorganisms embedded in a protective matrix. Biofilms provide a sheltered environment, reducing exposure to disinfectants and environmental stressors. For instance, Legionella, the bacterium causing Legionnaires’ disease, often coexists with amoebae in biofilms, but viruses like bacteriophages can also exploit this niche. To combat this, disinfection protocols should include biofilm-disrupting agents, such as enzymes or surfactants, followed by thorough cleaning.
Practical tips for minimizing viral persistence include using EPA-approved disinfectants with proven efficacy against enveloped and non-enveloped viruses. For surfaces, a 1:100 dilution of household bleach (5% sodium hypochlorite) is effective against most viruses, including SARS-CoV-2. In healthcare settings, UV-C light can be employed to inactivate viruses on surfaces and in air, reducing transmission risks. Regular hand hygiene with alcohol-based sanitizers (at least 60% ethanol) is also critical, as it disrupts viral capsids and inactivates pathogens within seconds.
In conclusion, while viruses do not form spores, their environmental persistence is facilitated by protective capsids, aggregation, and biofilm association. By understanding these mechanisms, we can implement targeted strategies to mitigate viral survival in various settings. From household cleaning to healthcare disinfection, proactive measures are essential to break the chain of infection and protect public health.
Can Fungal Spores Develop into Mature Hyphae? Unveiling the Process
You may want to see also
Explore related products

Capsid Protection: Viral capsids shield genetic material, enabling survival without spore-like structures
Viruses, unlike bacteria, do not form spores. Yet, their survival strategies are equally fascinating, hinging on the protective prowess of their capsids. These protein shells encase viral genetic material, shielding it from environmental assaults such as UV radiation, enzymes, and desiccation. This natural armor allows viruses to persist outside host cells for extended periods, sometimes years, without the need for spore-like structures. For instance, the poliovirus can survive in fecal matter for weeks, thanks to its capsid’s resilience, enabling it to spread efficiently in unsanitary conditions.
Consider the capsid as a bespoke suit of armor, tailored to the virus’s specific needs. Its structure is not merely protective but also functional, facilitating attachment to host cells and release of genetic material upon entry. Unlike bacterial spores, which are dormant and metabolically inactive, viruses encased in capsids remain poised for action, ready to infect when conditions are favorable. This distinction highlights the elegance of viral survival mechanisms, which rely on structural ingenuity rather than metabolic shutdown.
To illustrate, the influenza virus’s capsid is composed of a lipid envelope studded with proteins, which not only protects its RNA but also aids in evading the host immune system. This dual functionality underscores the capsid’s role as both shield and tool. In contrast, bacterial spores are singularly focused on survival, sacrificing functionality for longevity. For practical purposes, understanding capsid protection is crucial in developing antiviral strategies, as disrupting this shield can render viruses harmless.
From a comparative standpoint, the capsid’s role in viral survival is akin to a fortress guarding a city. While bacterial spores are like underground bunkers, ensuring survival through extreme conditions, capsids are active defenses, enabling viruses to thrive in diverse environments. This analogy emphasizes the capsid’s dynamic nature, which contrasts sharply with the static resilience of spores. For those studying viral transmission, focusing on capsid integrity offers insights into how viruses persist in water, air, and surfaces, informing disinfection protocols.
In conclusion, the capsid’s protective function is a testament to viral adaptability, eliminating the need for spore-like structures. Its ability to safeguard genetic material while maintaining infectivity is a key factor in viral survival and transmission. By studying capsid mechanics, researchers can identify vulnerabilities, paving the way for targeted antiviral therapies. Practical tips include using disinfectants that degrade capsid proteins, such as alcohol-based solutions (at least 70% concentration), to effectively inactivate viruses on surfaces. This knowledge not only deepens our understanding of viral biology but also empowers us to combat these microscopic adversaries more effectively.
Understanding Moss Spores: Are They Diplohaplontic? A Detailed Look
You may want to see also

Misconceptions Clarified: Spores are exclusive to prokaryotes; viruses use alternative mechanisms for longevity
Viruses and prokaryotes are often lumped together in discussions of microbial survival strategies, but their mechanisms for enduring harsh conditions differ fundamentally. A common misconception is that spores, a well-known survival structure, are utilized by both. In reality, spore formation is exclusive to certain prokaryotes, particularly bacteria like *Bacillus* and *Clostridium*. These spores are highly resistant to extreme temperatures, desiccation, and chemicals, allowing them to persist in environments where the vegetative form of the bacterium cannot. Viruses, on the other hand, lack the cellular machinery to produce spores and instead rely on alternative strategies to ensure their longevity.
To understand why viruses cannot form spores, consider their structural simplicity. Viruses are obligate intracellular parasites, consisting of genetic material (DNA or RNA) encased in a protein coat, sometimes with an additional lipid envelope. They lack the metabolic pathways and cellular structures necessary for sporulation, a complex process involving multiple genes and cellular reorganization. Instead, viruses employ strategies such as latency, where they integrate their genetic material into the host’s genome (e.g., herpesviruses), or form crystal-like structures called provirions (e.g., bacteriophages) that enhance stability outside a host. These mechanisms, while not spores, serve a similar purpose: ensuring survival until favorable conditions return.
A practical example highlights the distinction. Bacterial spores, such as those of *Bacillus anthracis* (the causative agent of anthrax), can remain dormant in soil for decades, withstanding UV radiation and extreme temperatures. In contrast, a virus like influenza relies on rapid transmission between hosts to survive, as it cannot form spores. However, influenza viruses can persist in water or on surfaces for hours to days, depending on environmental factors like humidity and temperature. This underscores the virus’s dependence on external conditions and its inability to achieve the same level of resilience as a bacterial spore.
For those working in microbiology or public health, understanding this distinction is crucial. Disinfection protocols, for instance, must account for the unique survival mechanisms of viruses and spore-forming bacteria. While alcohol-based sanitizers effectively inactivate most viruses by disrupting their lipid envelopes, they are ineffective against bacterial spores, which require autoclaving at 121°C and 15 psi for 15–30 minutes. Similarly, in food preservation, methods like pasteurization (72°C for 15 seconds) suffice to inactivate most viruses and vegetative bacteria but are insufficient for spore destruction, necessitating more aggressive techniques like sterilization.
In summary, the misconception that viruses can form spores stems from conflating their survival strategies with those of prokaryotes. While both have evolved mechanisms to endure adversity, spores are a prokaryotic innovation, and viruses rely on entirely different approaches. Recognizing this distinction not only clarifies microbial biology but also informs practical applications in medicine, hygiene, and industry. By tailoring interventions to the specific survival mechanisms of these microbes, we can more effectively control their spread and impact.
Exploring the Potential for Spore Mines to Advance in Modern Warfare
You may want to see also
Frequently asked questions
No, viruses cannot form spores. Spores are a survival mechanism used by certain bacteria, fungi, and plants, but viruses lack the cellular structure and metabolic processes necessary to produce spores.
Viruses can survive outside hosts in a dormant state called a virion, but this is not equivalent to spore formation. Virions are protected by a protein coat (capsid) and sometimes a lipid envelope, allowing them to persist in harsh environments until they encounter a new host.
Viruses are not living organisms and lack the cellular machinery required for spore formation. They depend on host cells to replicate and do not have the metabolic capabilities to produce complex structures like spores.
Some viruses, such as bacteriophages and certain DNA viruses, can survive in extreme environments (e.g., high temperatures, desiccation) due to their robust capsids or envelopes. However, this is not the same as forming spores, as they do not undergo a structural transformation.
Viruses can enter a dormant state within a host (latent infection), but this is different from spore formation. Latency involves the virus integrating its genetic material into the host’s genome or remaining inactive until conditions are favorable for replication, whereas spores are a distinct, protective structure formed by certain organisms.































